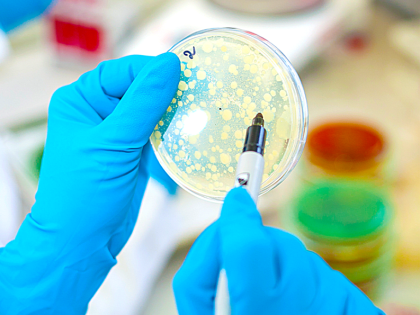

Здоровье

Хотите бросить курить – найдите другого курильщика
С 27 мая по 2 июня Минздрав России объявил Неделю отказа от табака. Поскольку избавление от вредной привычки для большинства курильщиков остаётся непосильной задачей,

30 мая – день борьбы с рассеянным склерозом
Ежегодно 30 мая во многих странах мира отмечают Всемирный день борьбы с рассеянным склерозом.

Врачи Ставрополья предупредили о страшном влиянии никотина на здоровье человека
Каждый год в мире табак уносит жизни около пяти миллионов человек. При курении образуется сложная газообразная смесь.

В Донецке начались восстановительные работы 11-этажного кардиоцентра
В 11-этажном кардиохирургическом корпусе будут созданы условия для лечения сердечно-сосудистых патологий у взрослых и детей, нуждающихся в высокотехнологичной медицинской помощи.

Отремонтировали единственное в СКФО медучреждение, где специалисты гражданской авиации могут пройти врачебно-летную комиссию
Завершились капитальные работы поликлиники №2 Минераловодской районной больницы.

Более 82 тысяч детей Кабардино-Балкарии прошли профилактические осмотры с начала года
Более 82 тысяч детей Кабардино-Балкарии прошли профилактические осмотры с начала года Профилактические осмотры проводят с целью раннего выявления патологических состояний, заболеваний и факторов риска их развития,

Дети Кабардино-Балкарии проходят профилактические осмотры
Более 82 тысяч детей Кабардино-Балкарии прошли профилактические осмотры с начала года, сообщает Минздрав КБР.

В Тереке ремонтируют детскую поликлинику
В детской поликлинике Терека продолжается капитальный ремонт, сообщает Минздрав КБР.
С начала года в лаборатории Северо-Кавказского филиала на антибиотики проверили 425 образцов мяса и мясной продукции
С начала этого года отдел токсикологических и радиологических исследований Северо-Кавказского филиала ФГБУ «Центр оценки качества зерна» провел исследования 425 образцов мяса и мясной продукции на содержание остаточного

Впервые выявили около 5 тысяч заболеваний в 2024 году во время медосмотра ставропольчан
Обследование проходит благодаря реализации в крае регионального проекта «За здоровье» нацпроекта «Демография».